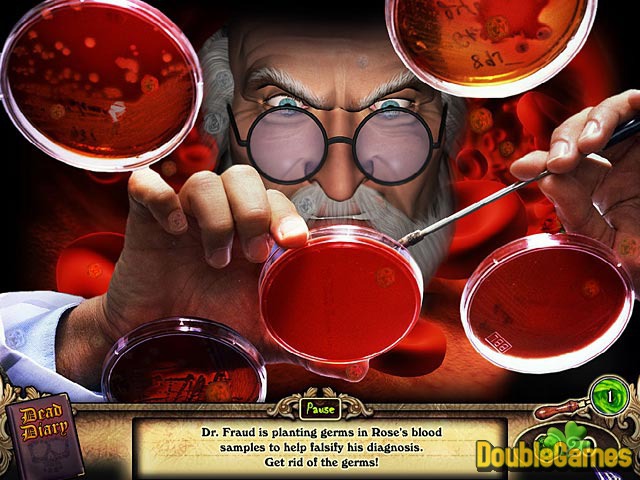

Top Games

4.5454545454545
11
Redrum
Genre: Hidden Object
2nd Runner-Up Best Puzzle Game of 2008! Rose sees dead people. Unfortunately her visions have landed her in an asylum. You must help Rose to use her psychic powers and ghostly visions to solve a series of grisly murders and thwart the plans of an evil doctor in this pulse-pounding Hidden Object game. Warning: Redrum is an intense psychological murder mystery intended for mature audiences.
REDRUM RELATED GAMES
Minimal system requirements
OS: Windows XP/Vista, CPU: 800 Mhz, RAM: 256 MB, DirectX: 7.0, Hard Drive: 60 MB
TOP CATEGORIES